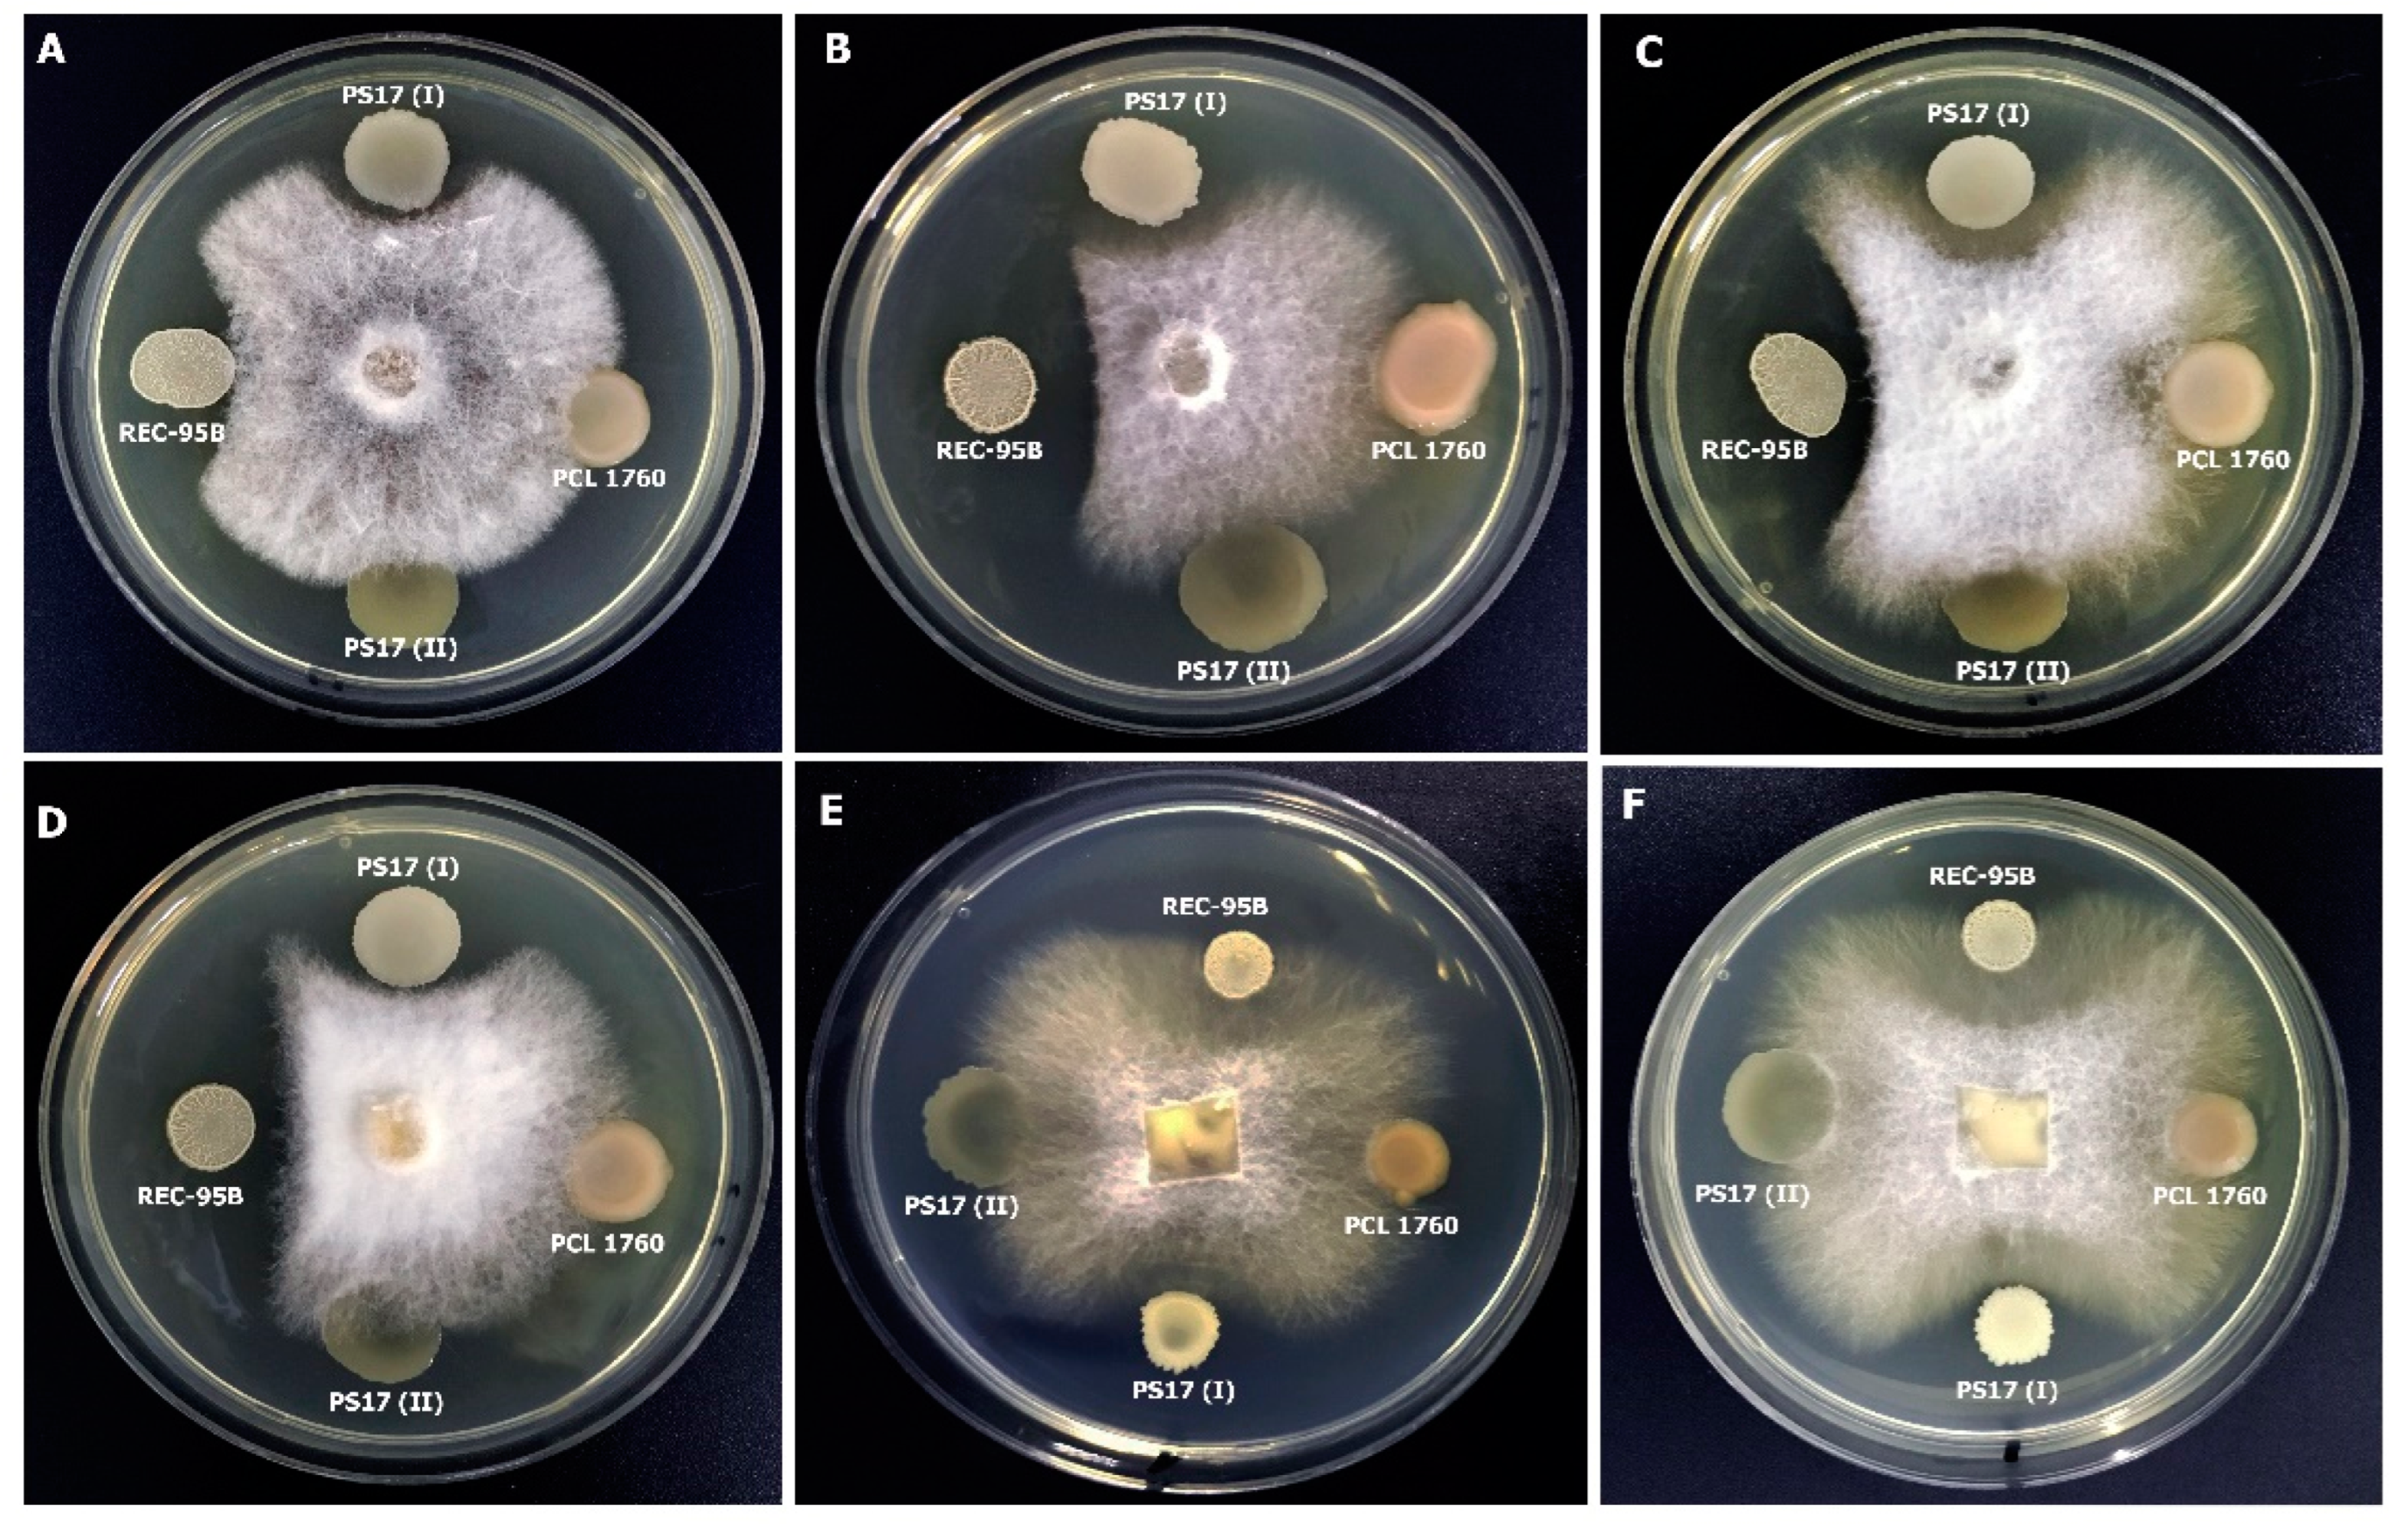
Biology 11 01305 g006
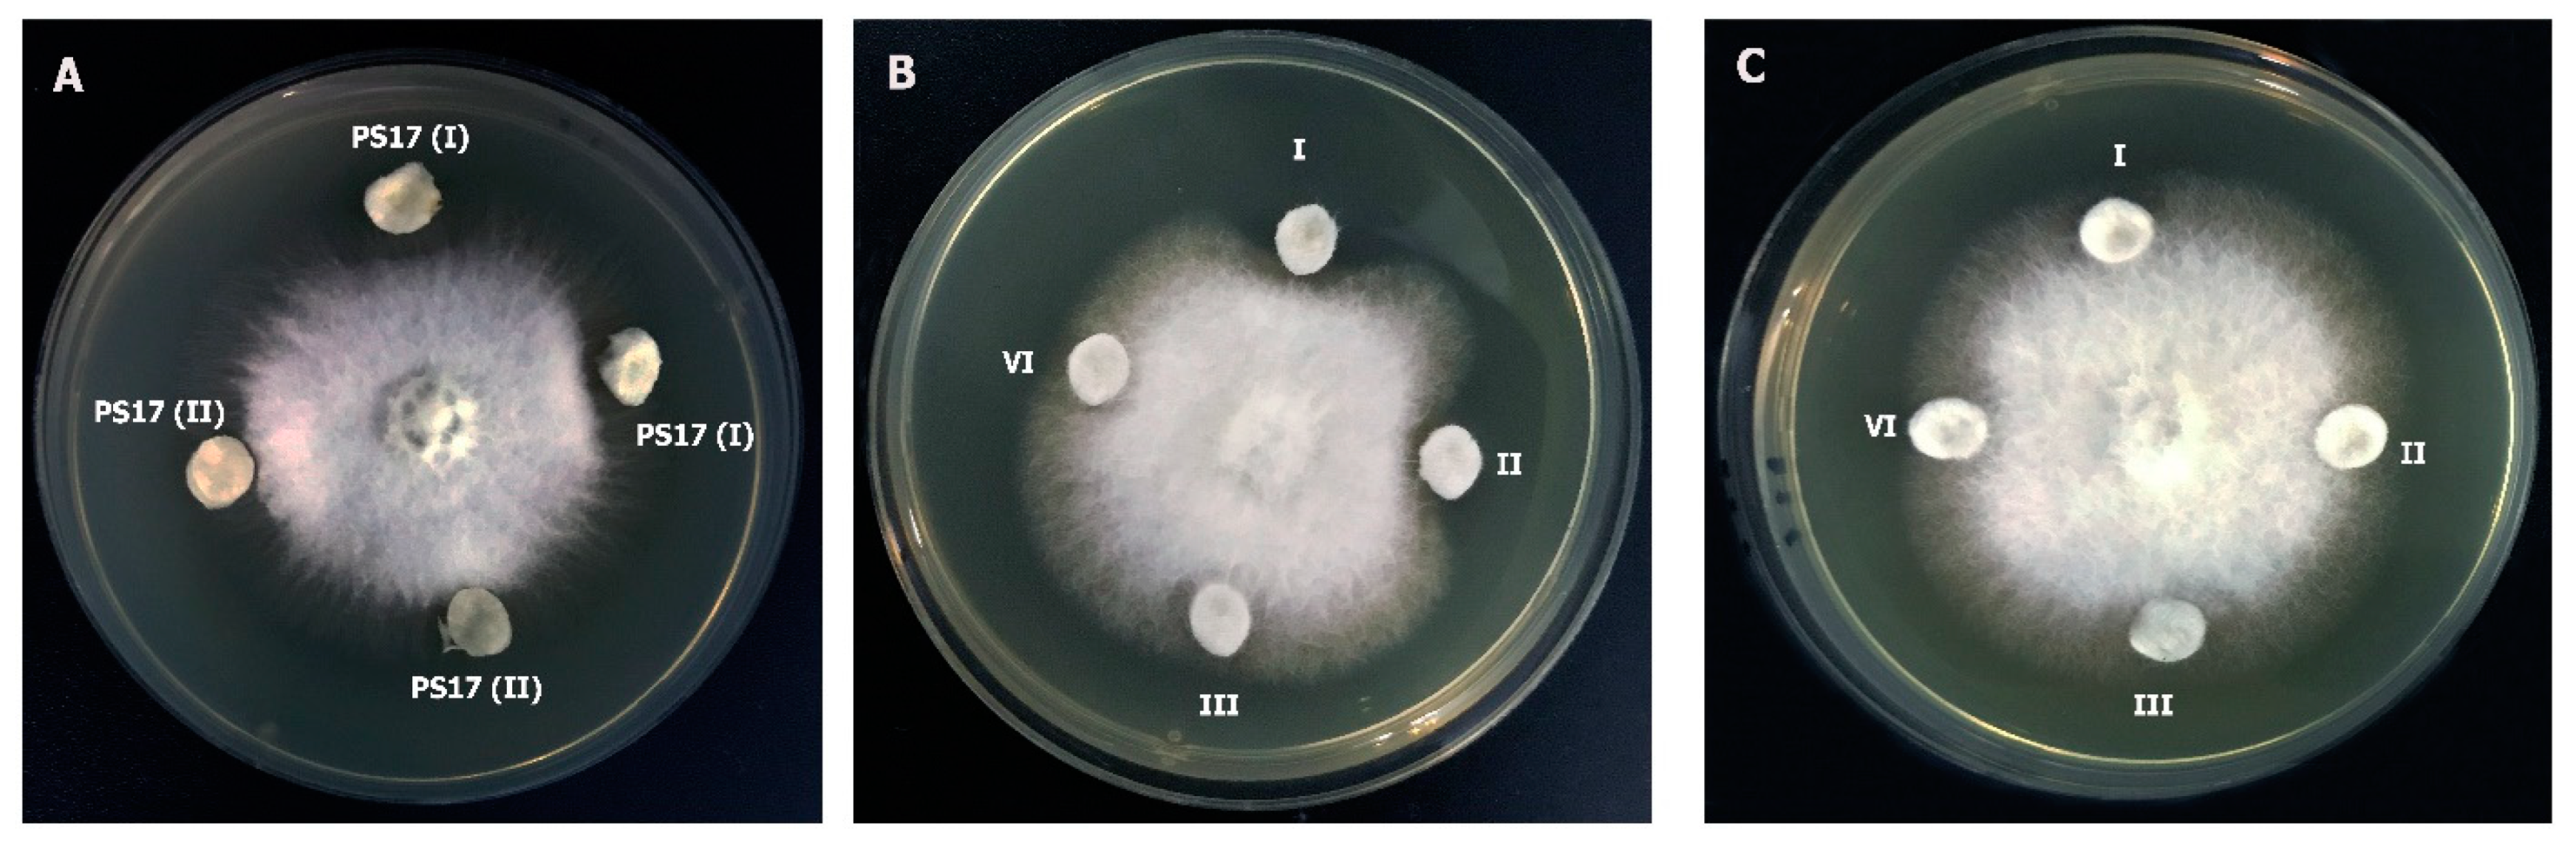
Biology 11 01305 g007
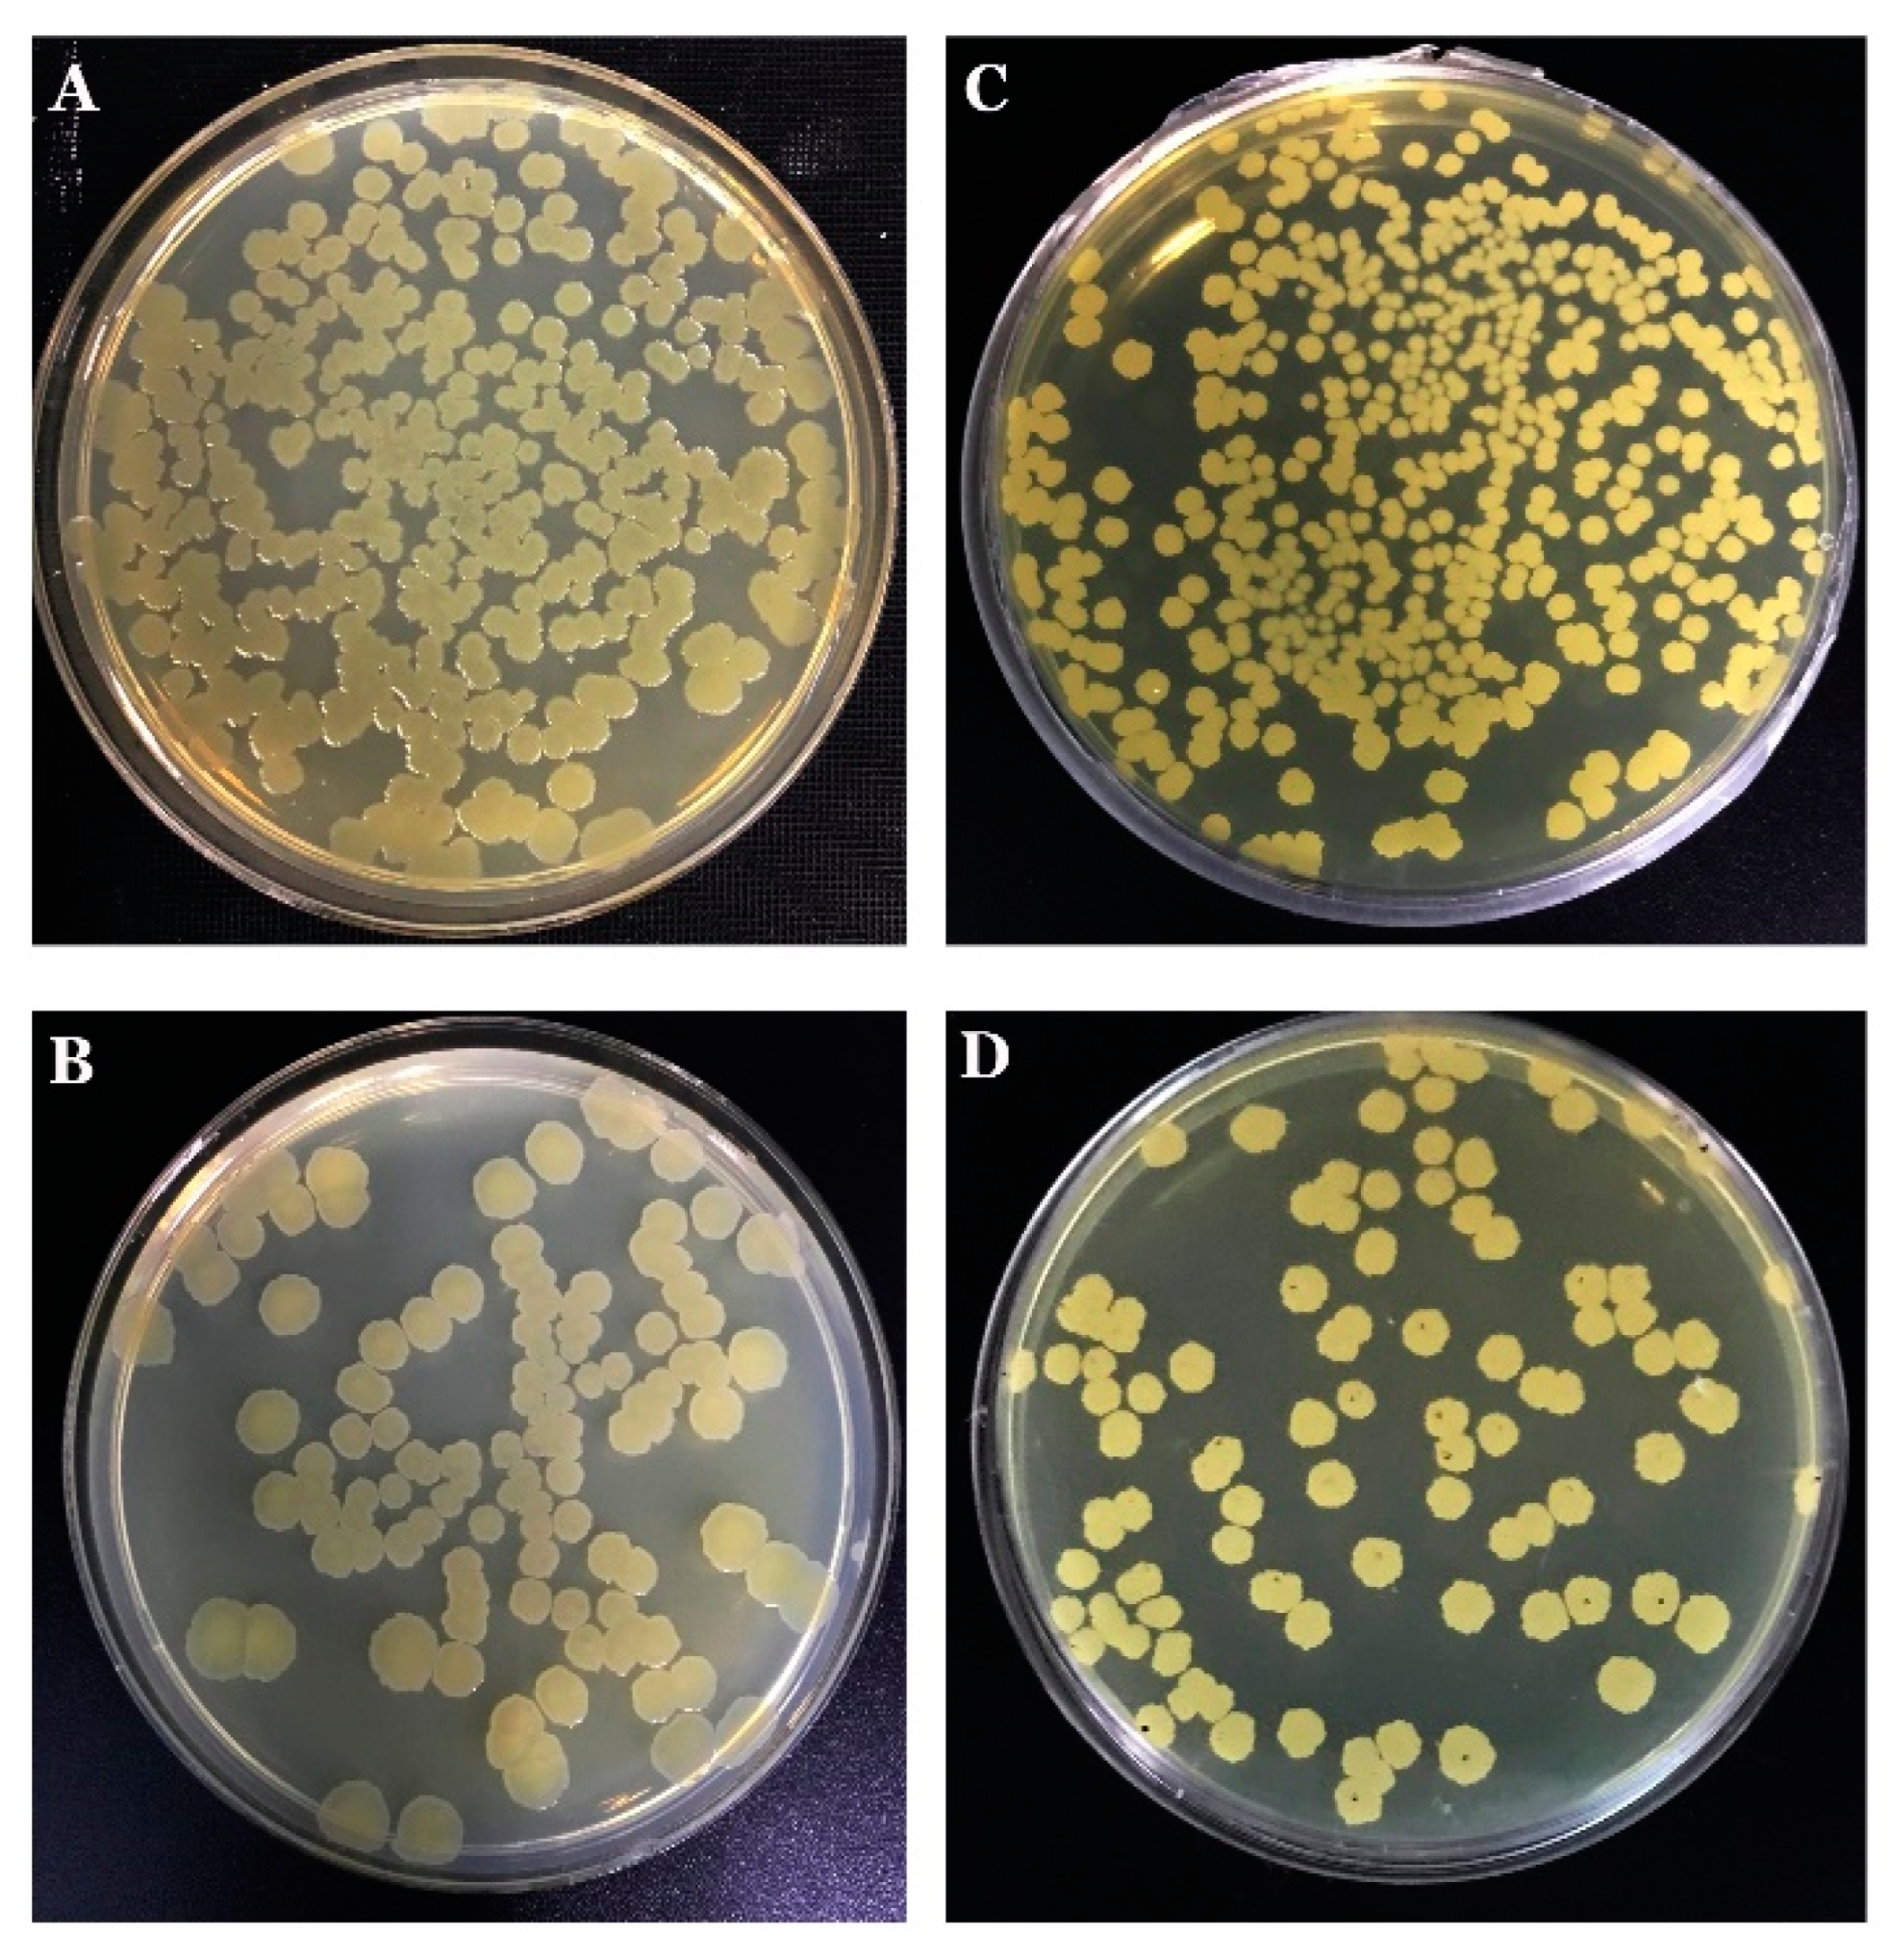
Biology 11 01305 g009

Effects of Phenotypic Variation on Biological Properties of Endophytic Bacteria Bacillus mojavensis PS17
Simple Summary
Abstract
1. Introduction
2. Materials and Methods
2.1. Bacterial and Fungal Strain Cultivation
2.2. Isolation of Different Morphotypes of B. mojavensis Strain PS17
2.3. Molecular Identification of the Isolates
2.4. DNA Fingerprinting Analysis
2.5. Transmission Electron Microscopy
2.6. Bacterial Inoculation and Bacterial Suspension Preparation
2.7. Growth Quantification
2.8. Measurement of Lysis Rates
2.9. Activity against Phytopathogenic Fungi
2.10. Effect of Phenotypic Variation of B. mojavensis PS17 on Hydrolytic Enzymes and Indole-3-Acetic Acid Production
2.10.1. Indole-3-Acetic Acid (IAA) Production
2.10.2. Hydrolytic Enzymes Production
Bacterial Culture Suspensions
2.11. Endophytic Abilities of B. mojavensis PS17 Morphotypes Strain
2.12. Plant Growth-Promoting Potential of B. mojavensis PS17 Morphotypes Strains
2.13. Biocontrol Properties of B. mojavensis PS17 Morphotypes on Tomato Plant against Forl ZUM2407
2.14. Statistical Analysis
3. Results
3.1. Morphology of Phase Variability and Verification of the Phasal Leniage
3.2. Structural Analysis under Transmission Electron Microscopy (TEM)
3.3. Characteristics of Colony Phase Change
3.3.1. Quantitative Assessment of Growth for B. mojavensis PS17 Morphotype I and II
3.3.2. Measurements of the Autolytic Rate of Morphotypes
3.3.3. Activity against Phytopathogenic Fungi
3.4. Effect of Phenotypic Variation of B. mojavensis PS17 on Hydrolytic Enzymes and Indole-3-Acetic Acid (IAA) Production
3.4.1. Indole-3-Acetic Acid (IAA) Production
3.4.2. Hydrolytic Enzymes Production
3.5. The Endophytic Ability of B. mojavensis PS17 Morphotypes
3.6. Plant Growth-Promoting Potential of B. mojavensis PS17 Morphotypes
3.7. Biocontrol Properties of B. mojavensis PS17 Morphotypes Strains on Tomato Plant against Forl ZUM2407
4. Discussion
5. Conclusions
Supplementary Materials
Author Contributions
Funding
Institutional Review Board Statement
Informed Consent Statement
Data Availability Statement
Acknowledgments
Conflicts of Interest
References
- Hussain, T.; Singh, S.; Danish, M.; Pervez, R.; Hussain, K.; Husain, R. Natural metabolites: An eco-friendly approach to manage plant diseases and for better agriculture farming. In Natural Bioactive Products in Sustainable Agriculture; Singh, J., Yadav, A., Eds.; Springer: Singapore, 2020; pp. 1–13. [Google Scholar] [CrossRef]
- Saunders, N.J.; Moxon, E.R.; Gravenor, M.B. Mutation rates: Estimating phase variation rates when fitness differences are present and their impact on population structure. Microbiol. Soc. 2003, 149, 485–495. [Google Scholar] [CrossRef]
- Wisniewski-Dyé, F.; Vial, L. Phase and antigenic variation mediated by genome modifications. Antonie Leeuwenhoek 2008, 94, 493–515. [Google Scholar] [CrossRef] [PubMed]
- Bayliss, C.D. Determinants of phase variation rate and the fitness implications of differing rates for bacterial pathogens and commensals. FEMS Microbiol. Rev. 2009, 33, 504–520. [Google Scholar] [CrossRef]
- Bayliss, C.D.; Bidmos, F.A.; Anjum, A.; Manchev, V.T.; Richards, R.L.; Grossier, J.P.; Tretyakov, M.V. Phase variable genes of Campylobacter jejuni exhibit high mutation rates and specific mutational patterns but mutability is not the major determinant of population structure during host colonisation. Nucleic Acids Res. 2012, 40, 5876–5889. [Google Scholar] [CrossRef]
- Van der Woude, M.W.; Bäumler, A.J. Phase and antigenic variation in bacteria. Clin. Microbiol. Rev. 2004, 17, 581–611. [Google Scholar] [CrossRef]
- Wisniewski-Dyé, F.; Vial, L.; Burdman, S.; Okon, Y.; Hartmann, A. Phenotypic variation in Azospirillum spp. and other root-associated bacteria. In Biological Nitrogen Fixation; De Bruijn, F.J., Ed.; Wiley: Hoboken, NJ, USA, 2015; pp. 1047–1054. [Google Scholar] [CrossRef]
- Drenkard, E.; Ausubel, F.M. Pseudomonas biofilm formation and antibiotic resistance are linked to phenotypic variation. Nature 2002, 416, 740–743. [Google Scholar] [CrossRef]
- Fox, K.L.; Atack, J.M.; Srikhanta, Y.N.; Eckert, A.; Novotny, L.A.; Bakaletz, L.O.; Jennings, M.P. Selection for phase variation of LOS biosynthetic genes frequently occurs in progression of non-typeable Haemophilus influenzae infection from the nasopharynx to the middle ear of human patients. PLoS ONE 2014, 9, e90505. [Google Scholar] [CrossRef]
- Dekkers, L.C.; Phoelich, C.C.; Van Der Fits, L.; Lugtenberg, B.J. A site-specific recombinase, is required for competitive root colonisation by Pseudomonas fluorescens WCS365. Proc. Natl. Acad. Sci. USA 1998, 95, 7051–7056. [Google Scholar] [CrossRef]
- Dekkers, L.C.; Mulders, I.H.; Phoelich, C.C.; Chin-A-Woeng, T.F.; Wijfjes, A.H.; Lugtenberg, B.J. The sss colonisation gene of the tomato-Fusarium oxysporum f. sp radicis-lycopersici biocontrol strain Pseudomonas fluorescens WCS365 can improve root colonisation of other wild-type Pseudomonas spp. bacteria. Mol. Plant Microbe Interact. 2000, 13, 1177–1183. [Google Scholar] [CrossRef]
- Achouak, W.; Conrod, S.; Cohen, V.; Heulin, T. Phenotypic variation of Pseudomonas brassicacearum as a plant root-colonisation strategy. Mol. Plant Microbe Interact. 2004, 17, 872–879. [Google Scholar] [CrossRef] [PubMed]
- Li, D.; Rothballer, M.; Engel, M.; Hoser, J.; Schmidt, T.; Kuttler, C.; Schmid, M.; Schloter, M.; Hartmann, A. Phenotypic variation in Acidovorax radicis N35 influences plant growth promotion. FEMS Microbiol. Ecol. 2012, 79, 751–762. [Google Scholar] [CrossRef]
- Lerner, A.; Valverde, A.; Castro-Sowinski, S.; Lerner, H.; Okon, Y.; Burdman, S. Phenotypic variation in Azospirillum brasilense exposed to starvation. Environ. Microbiol. Rep. 2010, 2, 577–586. [Google Scholar] [CrossRef]
- Pérez-García, A.; Romero, D.; De Vicente, A. Plant protection and growth stimulation by microorganisms: Biotechnological applications of Bacilli in agriculture. Curr. Opin. Biotechnol. 2011, 22, 187–193. [Google Scholar] [CrossRef]
- Reva, O.N.; Dixelius, C.; Meijer, J.; Priest, F.G. Taxonomic characterisation and plant colonising abilities of some bacteria related to Bacillus amyloliquefaciens and Bacillus subtilis. FEMS Microbiol. Ecol. 2004, 48, 249–259. [Google Scholar] [CrossRef]
- Bacon, C.W.; Hinton, D.M. Endophytic and biological control potential of Bacillus mojavensis and related species. Biol. Control 2002, 23, 274–284. [Google Scholar] [CrossRef]
- Bacon, C.W.; Hinton, D.M.; Hinton, A., Jr. Growth-inhibiting effects of concentrations of fusaric acid on the growth of Bacillus mojavensis and other biocontrol Bacillus species. J. Appl. Microbiol. 2006, 100, 185–194. [Google Scholar] [CrossRef]
- Ayed, H.B.; Hmidet, N.; Béchet, M.; Chollet, M.; Chataigné, G.; Leclère, V.; Nasri, M. Identification and biochemical characteristics of lipopeptides from Bacillus mojavensis A21. Process Biochem. 2014, 49, 1699–1707. [Google Scholar] [CrossRef]
- Rath, M.; Mitchell, T.R.; Gold, S.E. Volatiles produced by Bacillus mojavensis RRC101 act as plant growth modulators and are strongly culture-dependent. Microbiol. Res. 2018, 208, 76–84. [Google Scholar] [CrossRef]
- Prajakta, B.M.; Suvarna, P.P.; Raghvendra, S.P.; Alok, R.R. Potential biocontrol and superlative plant growth promoting activity of indigenous Bacillus mojavensis PB-35 (R11) of soybean (Glycine max) rhizosphere. SN Appl. Sci. 2019, 1, 1143. [Google Scholar] [CrossRef]
- Xia, Y.; DeBolt, S.; Dreyer, J.; Scott, D.; Williams, M.A. Characterization of culturable bacterial endophytes and their capacity to promote plant growth from plants grown using organic or conventional practices. Front. Plant Sci. 2015, 6, 490. [Google Scholar] [CrossRef]
- Lopes, R.; Tsui, S.; Gonçalves, P.J.; de Queiroz, M.V. A look into a multifunctional toolbox: Endophytic Bacillus species provide broad and underexploited benefits for plants. World J. Microbiol. Biotechnol. 2018, 34, 94. [Google Scholar] [CrossRef]
- Bacon, C.W.; Hinton, D.M. Bacillus mojavensis: Its endophytic nature, the surfactins, and their role in the plant response to infection by Fusarium verticillioides. In Bacteria in Agrobiology: Plant Growth Responses; Springer: Berlin/Heidelberg, Germany, 2011; pp. 21–39. [Google Scholar] [CrossRef]
- Yi, Y.; de Jong, A.; Frenzel, E.; Kuipers, O.P. Comparative transcriptomics of Bacillus mycoides strains in response to potato-root exudates reveals different genetic adaptation of endophytic and soil isolates. Front. Microbiol. 2017, 8, 1487. [Google Scholar] [CrossRef]
- Diabankana, R.G.C.; Afordoanyi, D.M.; Safin, R.I.; Nizamov, R.M.; Karimova, L.Z.; Validov, S.Z. Antifungal Properties, Abiotic Stress Resistance, and Biocontrol Ability of Bacillus mojavensis PS17. Curr. Microbiol. 2021, 78, 3124–3132. [Google Scholar] [CrossRef]
- Validov, S. Biological Control of Tomato Foot and Root Rot by Pseudomonasbacteria in Stonewool; Leiden University: Leiden, The Netherlands, 2007. [Google Scholar]
- Validov, S.Z.; Kamilova, F.; Lugtenberg, B.J. Pseudomonas putida strain PCL1760 controls tomato foot and root rot in stonewool under industrial conditions in a certified greenhouse. Biol. Control 2009, 48, 6–11. [Google Scholar] [CrossRef]
- Schaeffer, P.H.; Millet, J.; Aubert, J.P. Catabolic repression of bacterial sporulation. Proc. Natl. Acad. Sci. USA 1965, 54, 704–711. [Google Scholar] [CrossRef] [PubMed]
- Setlow, P.; Kornberg, A. Biochemical studies of bacterial sporulation and germination. XVII. Sulfhydryl and disulfide levels in dormancy and germination. J. Bacteriol. Res. 1969, 100, 1155–1160. [Google Scholar] [CrossRef]
- Weisburg, W.G.; Barns, S.M.; Pelletier, D.A.; Lane, D.J. 16S ribosomal DNA amplification for phylogenetic study. J. Bacteriol. Res. 1991, 173, 697–703. [Google Scholar] [CrossRef]
- Versalovic, J.; Koeuth, T.; Lupski, R. Distribution of repetitive DNA sequences in eubacteria and application to fingerprinting of bacterial genomes. Nucleic Acids Res. 1991, 19, 6823–6831. [Google Scholar] [CrossRef]
- Louws, F.J.; Fulbright, D.W.; Stephens, C.T.; De Bruijn, F.J. Specific genomic fingerprints of phytopathogenic Xanthomonas and Pseudomonas pathovars and strains generated with repetitive sequences and PCR. Appl. Environ. Microbiol. 1994, 60, 2286–2295. [Google Scholar] [CrossRef]
- Gordon, S.A.; Weber, R.P. Colorimetric estimation of indoleacetic acid. Plant Physiol. 1951, 26, 192–195. [Google Scholar] [CrossRef]
- Ehmann, A. The Van Urk-Salkowski reagent—A sensitive and specific chromogenic reagent for silica gel thin-layer chromatographic detection and identification of indole derivatives. J. Chromatogr. A 1977, 132, 267–276. [Google Scholar] [CrossRef]
- Ghose, T. Measurement of Cellulase Activities. Pure Appl. Chem. 1987, 59, 257–268. [Google Scholar] [CrossRef]
- Silva, M.F.; Mota, C.M.; Miranda, V.D.S.; Oliveira Cunha, A.D.; Silva, M.C.; Naves, K.S.C.; Santiago, F.M. Biological and enzymatic characterisation of proteases from crude venom of the ant Odontomachus bauri. Toxins 2015, 7, 5114–5128. [Google Scholar] [CrossRef] [PubMed]
- Denault, L.J.; Allen, W.G.; Boyer, E.W.; Collins, D.; Kramme, D.; Spradlin, J.E. A simple reducing sugar assay for measuring β-glucanase activity in malt, and various microbial enzyme preparations. J. Am. Soc. Brew. Chem. 1978, 36, 18–23. [Google Scholar] [CrossRef]
- Simons, M.; Van Der Bij, A.J.; Brand, I.; De Weger, L.A.; Wijffelman, C.A.; Lugtenberg, B.J. Gnotobiotic system for studying rhizosphere colonisation by plant growth-promoting Pseudomonas bacteria. Mol. Plant Microbe Interact. 1996, 9, 600–607. [Google Scholar] [CrossRef]
- Afordoanyi, D.M.; Diabankana, R.G.C.; Akosah, Y.A.; Validov, S.Z. Are formae speciales pathogens really host specific? A broadened host specificity in Fusarium oxysporum f.sp. radicis-cucumerinum. Braz. J. Microbiol. 2022, 1–15. [Google Scholar] [CrossRef]
- Aertsen, A.; Michiels, C.W. Stress and how bacteria cope with death and survival. Crit. Rev. Microbiol. 2004, 30, 263–273. [Google Scholar] [CrossRef]
- Chabeaud, P.; de Groot, A.; Bitter, W.; Tommassen, J.; Heulin, T.; Achouak, W. Phase-variable expression of an operon encoding extracellular alkaline protease, a serine protease homolog, and lipase in Pseudomonas brassicacearum. J. Bacteriol. 2001, 183, 2117–2120. [Google Scholar] [CrossRef]
- Roche, R.J.; Moxon, E.R. Phenotypic variation in Haemophilus influenzae: The interrelationship of colony opacity, capsule, and lipopolysaccharide. Microb. Pathog. 1995, 18, 129–140. [Google Scholar] [CrossRef]
- Weiser, J.N.; Chong, S.T.; Greenberg, D.; Fong, W. Identification and characterisation of a cell envelope protein of Haemophilus influenzae contributing to phase variation in colony opacity and nasopharyngeal colonisation. Mol. Microbiol. 1995, 17, 555–564. [Google Scholar] [CrossRef]
- Moxon, E.R.; Gewurz, B.E.; Richards, J.C.; Inzana, T.; Jennings, M.P.; Hood, D.W. Phenotypic switching of Haemophilus influenzae. Mol. Microbiol. 1996, 19, 1149–1150. [Google Scholar] [CrossRef] [PubMed]
- Prasadarao, N.V.; Lysenko, E.; Wass, C.A.; Kim, K.S.; Weiser, J.N. Opacity-associated protein A contributes to the binding of Haemophilus influenzae to Chang epithelial cells. Infect. Immun. 1999, 67, 4153–4160. [Google Scholar] [CrossRef]
- Hammerschmidt, S.; Müller, A.; Sillmann, H.; Miihlenhoff, M.; Borrow, R.; Fox, A.; Frosch, M. Capsule phase variation in Neisseria meningitidis serogroup B by slipped-strand mispairing in the polysialyltransferase gene (siaD): Correlation with bacterial invasion and the outbreak of meningococcal disease. Mol. Microbiol. 1996, 20, 1211–1220. [Google Scholar] [CrossRef] [PubMed]
- Enos-Berlage, J.L.; McCarter, L.L. Relation of capsular polysaccharide production and colonial cell organisation to colony morphology in Vibrio parahaemolyticus. J. Bacteriol. Res. 2000, 182, 5513–5520. [Google Scholar] [CrossRef]
- Hernday, A.; Krabbe, M.; Braaten, B.; Low, D. Self-perpetuating epigenetic pili switches in bacteria. Proc. Natl. Acad. Sci. USA 2002, 99 (Suppl. S4), 16470–16476. [Google Scholar] [CrossRef] [PubMed]
- Kline, K.A.; Sechman, E.V.; Skaar, E.P.; Seifert, H.S. Recombination, repair and replication in the pathogenic Neisseriae: The 3 R’s of molecular genetics of two human-specific bacterial pathogens. Mol. Microbiol. 2003, 50, 3–13. [Google Scholar] [CrossRef]
- Pogorelova, A.Y.; Mulyukin, A.L.; Antonyuk, L.P.; Galchenko, V.F. Phenotypic variability in Azospirillum brasilense strains Sp7 and Sp245: Association with dormancy and characteristics of the variants. Microbiology 2009, 78, 559–568. [Google Scholar] [CrossRef]
- Van der Woude, M.; Braaten, B.; Low, D. Phase Variation. In Bacterial Genomes; de Bruijn, F.J., Lupski, J.R., Weinstock, G.M., Eds.; Springer: Boston, MA, USA, 1998. [Google Scholar] [CrossRef]
- Van der Woude, M.; Braaten, B.; Low, D. Epigenetic phase variation of the pap operon in Escherichia coli. Trends Microbiol. 1996, 4, 5–9. [Google Scholar] [CrossRef]
- Gor, V.; Ohniwa, R.L.; Morikawa, K. No Change, No Life? What We Know about Phase Variation in Staphylococcus aureus. Microorganisms 2021, 9, 244. [Google Scholar] [CrossRef]
- Sciochetti, S.A.; Piggot, P.J.; Sherratt, D.J.; Blakely, G. The ripX locus of Bacillus subtilis encodes a site-specific recombinase involved in proper chromosome partitioning. J. Bacteriol. 1999, 181, 6053–6062. [Google Scholar] [CrossRef]
- Lamsa, A.; Liu, W.T.; Dorrestein, P.C.; Pogliano, K. The Bacillus subtilis cannibalism toxin SDP collapses the proton motive force and induces autolysis. Mol. Microbiol. 2012, 84, 486–500. [Google Scholar] [CrossRef] [PubMed]
- Dybvig, K.; Sitaraman, R.; French, C.T. A family of phase-variable restriction enzymes with differing specificities generated by high-frequency gene rearrangements. Proc. Natl. Acad. Sci. USA 1998, 95, 13923–13928. [Google Scholar] [CrossRef] [PubMed]
- Steinmoen, H.; Teigen, A.; Håvarstein, L.S. Competence-Induced Cells of Streptococcus pneumoniae Lyse Competence-Deficient Cells of the Same Strain during Cocultivation. J. Bacteriol. 2003, 185, 7176–7183. [Google Scholar] [CrossRef] [PubMed]
- Trzilova, D.; Tamayo, R. Site-specific recombination–how simple DNA inversions produce complex phenotypic heterogeneity in bacterial populations. Trends Genet. 2021, 37, 59–72. [Google Scholar] [CrossRef]
- Pal, K.K.; Gardener, B.M. Biological control of plant pathogens. Plant Health Instr. 2006, 2, 1117–1142. [Google Scholar] [CrossRef]
- Kodama, T.; Endo, K.; Ara, K.; Ozaki, K.; Kakeshita, H.; Yamane, K.; Sekiguchi, J. Effect of Bacillus subtilis spo0A mutation on cell wall lytic enzymes and extracellular proteases, and prevention of cell lysis. J. Biosci. Bioeng. 2007, 103, 13–21. [Google Scholar] [CrossRef]
- Verbon, E.H.; Liberman, L.M. Beneficial microbes affect endogenous mechanisms controlling root development. Trends Plant Sci. 2016, 21, 218–229. [Google Scholar] [CrossRef]
- Jadhav, H.P.; Shaikh, S.S.; Sayyed, R.Z. Role of Hydrolytic Enzymes of Rhizoflora in Biocontrol of Fungal Phytopathogens: An Overview. In Rhizotrophs: Plant Growth Promotion to Bioremediation. Microorganisms for Sustainability; Mehnaz, S., Ed.; Springer: Singapore, 2017; Volume 2. [Google Scholar] [CrossRef]
- Laville, J.; Voisard, C.; Keel, C.; Maurhofer, M.; Défago, G.; Haas, D. Global control in Pseudomonas fluorescens mediating antibiotic synthesis and suppression of black root rot of tobacco. Proc. Natl. Acad. Sci. USA 1992, 89, 1562–1566. [Google Scholar] [CrossRef]
- Gaffney, T.D.; Lam, S.T.; Ligon, J.; Gates, K.; Frazelle, A.; DiMaio, J.; Hill, S.; Goodwin, S.; Torkewitz, N.; Allshouse, A.M.; et al. Global regulation of expression of antifungal factors by a Pseudomonas fluorescens biological control strain. Mol. Plant Microbe Interact. 1994, 7, 455–463. [Google Scholar] [CrossRef]
- Corbell, N.; Loper, J.E. A global regulator of secondary metabolite production in Pseudomonas fluorescens Pf-5. J. Bacteriol. 1995, 177, 6230–6236. [Google Scholar] [CrossRef]
- Cook, R.J.; Thomashow, L.S.; Weller, D.M.; Fujimoto, D.; Mazzola, M.; Bangera, G.; Kim, D. Molecular mechanisms of defense by rhizobacteria against root disease. Proc. Natl. Acad. Sci. USA 1995, 92, 4197–4201. [Google Scholar] [CrossRef] [PubMed]
- Van den Broek, D.; Chin-A-Woeng, T.F.; Eijkemans, K.; Mulders, I.H.; Bloemberg, G.V.; Lugtenberg, B.J. Biocontrol traits of Pseudomonas spp. are regulated by phase variation. Mol. Plant Microbe Interact. 2003, 16, 1003–1012. [Google Scholar] [CrossRef] [PubMed][Green Version]
- Narayanasamy, P. Mechanisms of Action of Bacterial Biological Control Agents. In Biological Management of Diseases of Crops; Progress in Biological Control; Springer: Dordrecht, The Netherlands, 2013. [Google Scholar] [CrossRef]
- Köhl, J.; Kolnaar, R.; Ravensberg, W.J. Mode of action of microbial biological control agents against plant diseases: Relevance beyond efficacy. Front. Plant Sci. 2019, 10, 845. [Google Scholar] [CrossRef] [PubMed]
- Besset-Manzoni, Y.; Joly, P.; Brutel, A.; Gerin, F.; Soudière, O.; Langin, T.; Prigent-Combaret, C. Does in vitro selection of biocontrol agents guarantee success in planta? A study case of wheat protection against Fusarium seedling blight by soil bacteria. PLoS ONE 2019, 14, e0225655. [Google Scholar] [CrossRef]
- Troxler, J.; Zala, M.; Natsch, A.; Moënne-Loccoz, Y.; Défago, G. Autecology of the biocontrol strain Pseudomonas fluorescens CHA0 in the rhizosphere and inside roots at later stages of plant development. FEMS Microbiol. Ecol. 1997, 23, 119–130. [Google Scholar] [CrossRef][Green Version]
- Barnett, S.; Singleton, I.; Ryder, M.; Ogoshi, A.; Kobayashi, K.; Homma, Y.; Akino, S. The effect of growth conditions on phenotype plasticity in Pseudomonas corrugata 2140, and the phenotypic characterisation of a range of new phenotype variants. In Proceedings of the Fourth International Workshop on the Plant Growth-Promoting Rhizobacteria, Sapporo, Japan, 5–10 October 1997; p. 417. [Google Scholar]
- Vacheron, J.; Desbrosses, G.; Bouffaud, M.L.; Touraine, B.; Moenne-Loccoz, Y.; Muller, D.; Legendre, L.; Wisniewski-Dye, F.; Prigent-Combaret, C. Plant growth-promoting rhizobacteria and root system functioning. Front. Plant Sci. 2013, 4, 356. [Google Scholar] [CrossRef]
- Bashan, Y.; de-Bashan, L.E.; Prabhu, S.R.; Hernandez, J.P. Advances in plant growth-promoting bacterial inoculant technology: Formulations and practical perspectives (1998–2013). Plant Soil 2014, 378, 1–33. [Google Scholar] [CrossRef]

| Strain Name | Description | Source/Reference |
|---|---|---|
| B. mojavensis PS17, referred to as morphotype I | Biocontrol agent uses the mechanism of antibiosis for plant protection | Diabankana et al. [26] Collection of Agroecological Research center of Kazan State Agrarian University Deposited in All Russian Collection of Industrial Microorganisms as Bacillus mojavensis B-13415 |
| B. mojavensis PS17 morphotype II, referred to as morphotype II | Morphotypic variant of B. mojavensis PS17 forming translucent colonies on 2× Schaeffer’s agar surface. | Isolated in this work |
| Pseudomonas putida PCL1760 | The biocontrol agent uses the mechanism of completion for nutrients and niches (CNN). In this work, it is used as a reference biocontrol strain in biocontrol assay of tomato plantlets. | Validov et al. [27] Deposited in All Russian Collection of industrial microorganisms as Pseudomonas plecoglossicida B-13802 |
| Fusarium oxysporum f.sp. radices-lycopersici (Forl) ZUM2407 | The causal agent of foot and root rot of tomato. | Validov et al. [28] |
| Cell Characterization | PS17 (I) | PS17 (II) | |
|---|---|---|---|
| Length (µm) | Minimum | 1.09 | 1.17 |
| Maximum | 1.54 | 2.09 | |
| Average ± stdev | 1.35 ± 0.158 | 1.64 ± 0.26 | |
| Diameter (µm) | Minimum | 0.512 | 0.624 |
| Maximum | 0.676 | 0.874 | |
| Average ± stdev | 0.61 ± 0.051 | 0.73 ± 0.07 a | |
| Plasmolyzed cells | 53 (15.18%) of 349 cells counted | 54 (19.35%) of 279 cells counted | |
| Cells with enlarged periplasmic | 28 (8.02%) of 349 cells counted | 32 (11.46%) of 279 cells counted | |
Publisher’s Note: MDPI stays neutral with regard to jurisdictional claims in published maps and institutional affiliations. |
© 2022 by the authors. Licensee MDPI, Basel, Switzerland. This article is an open access article distributed under the terms and conditions of the Creative Commons Attribution (CC BY) license (https://creativecommons.org/licenses/by/4.0/).
Share and Cite
Diabankana, R.G.C.; Validov, S.Z.; Vyshtakalyuk, A.B.; Daminova, A.; Safin, R.I.; Afordoanyi, D.M. Effects of Phenotypic Variation on Biological Properties of Endophytic Bacteria Bacillus mojavensis PS17. Biology 2022, 11, 1305. https://doi.org/10.3390/biology11091305
Diabankana RGC, Validov SZ, Vyshtakalyuk AB, Daminova A, Safin RI, Afordoanyi DM. Effects of Phenotypic Variation on Biological Properties of Endophytic Bacteria Bacillus mojavensis PS17. Biology. 2022; 11(9):1305. https://doi.org/10.3390/biology11091305
Chicago/Turabian StyleDiabankana, Roderic Gilles Claret, Shamil Zavdatovich Validov, Alexandra Borisovna Vyshtakalyuk, Amina Daminova, Radik Ilyasovich Safin, and Daniel Mawuena Afordoanyi. 2022. "Effects of Phenotypic Variation on Biological Properties of Endophytic Bacteria Bacillus mojavensis PS17" Biology 11, no. 9: 1305. https://doi.org/10.3390/biology11091305
APA StyleDiabankana, R. G. C., Validov, S. Z., Vyshtakalyuk, A. B., Daminova, A., Safin, R. I., & Afordoanyi, D. M. (2022). Effects of Phenotypic Variation on Biological Properties of Endophytic Bacteria Bacillus mojavensis PS17. Biology, 11(9), 1305. https://doi.org/10.3390/biology11091305

